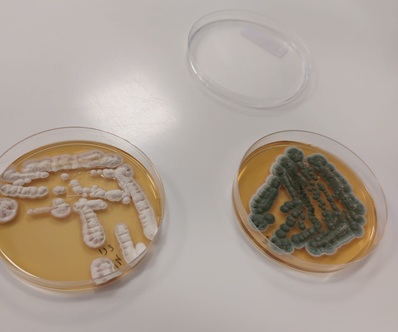

04/2026 - Approfondimento di comunicazione d'Impresa - Redazione di Largo Consumo
Sacco System: scienza e innovazione per l'agroalimentare
Enzimi, fermenti lattici, principi attivi e probiotici: un mondo al microscopio che ha portato un'azienda nata nel 1872 nella provincia comasca sullo scenario mondiale tra i migliori partner industriali del settore delle biotecnologie made in Italy a servizio dell'intera filiera dell'agroalimentare.
Sacco System è il polo italiano di eccellenza che ricerca, studia e sviluppa microrganismi per le industrie alimentari, nutraceutiche, farmaceutiche e agro-veterinarie per migliorare la qualità della vita di esseri umani, animali e piante.
Non una singola azienda, ma un network di realtà complementari - Caglificio Clerici, Sacco Srl, Centro Sperimentale del Latte (CSL), CSL USA, Synbiotec - che condividono risorse, know-how e valori, con una rete articolata di siti produttivi e di ricerca e di uffici commerciali distribuiti tra Italia ed estero. Una storia imprenditoriale - quella della famiglia Clerici-Verga - che attraversa cinque generazioni, unite dalla passione per la scienza e l'innovazione.
Con un fatturato 2025 di oltre 195 milioni di euro (di cui circa il 70% generato all’estero), 600 collaboratori, 11 impianti produttivi, 8 filiali commerciali, una presenza in 110 Paesi nel mondo e una banca proprietaria di 6500 ceppi batterici, Sacco System si pone come partner specializzato coniugando passione e competenza.

3 le linee di business; Food - Ingredienti per l'Industria Alimentare, Microbiome -Salute Umana, Nutraceutica e Farmaceutica e Agro-Vet - Benessere Animale e Sostenibilità Agricola.
Ricerca e innovazione sono i temi driver, e non a caso il 6% del fatturato viene destinato a investimenti per lo sviluppo di prodotti, processi, strumenti e strutture sempre più sofisticati.
Nata come produttore di caglio per l'industria alimentare, l'azienda è diventata nel tempo un "microbial innovator" di colture starter per la fermentazione alimentare (in particolare lattiero-casearia) e integratori alimentari (colture probiotiche), nonché strumenti per il miglioramento degli alimenti. nel quotidiano, tutto questo si traduce in un goloso yogurt, un formaggio dop, un succo di frutta, che ogni brand può personalizzare per conquistare il gusto del proprio pubblico.
I crescenti successi hanno portato negli ultimi anni ad un rapido sviluppo e ad un'espansione importante in ambito globale tra Europa, America, Australia e Asia e il 2026 vede la celebrazione del decimo anniversario della nascita di Sacco System con un una nuova brand image, l'ennesima apertura estera, a Shanghai e un investimento da 80 milioni di euro nei prossimi tre anni.
Trasformare la scienza dei microrganismi in soluzioni concrete e applicabili tanto per i clienti industriali quanto per il consumatore finale è la visione che sta alla base del nuovo purpose: "Nurturing the world" nasce infatti dalla volontà di rispondere a mercati in trasformazione e a consumatori sempre più attenti al proprio benessere, oltre che alla scelta di prodotti naturali e sostenibili.
I microrganismi Sacco System si trovano così in yogurt (uno dei segmenti in maggiore crescita), formaggi (dalle diverse stagionature e declinazioni), poi insaccati, bevande e prodotti fermentati così come nei fermenti lattici e i probiotici oggi alla base, per esempio, del trend abbracciato dal grande pubblico del benessere del microbiota intestinale o della prevenzione della salute.
Oltre alla ricca ceppoteca conservata in più copie nel mondo, Sacco System dispone di 4 impianti pilota per le fasi di scale-up e sviluppo di processo, stabilimenti e laboratori certificati e collaborazioni strutturate con oltre 40 università e centri di ricerca italiani e internazionali.
Sono più di 90 i progetti di ricerca attualmente in corso, in svariate aree che ricadono tutte nel denominatore comune del benessere delle persone e dell'ecosistema, con particolare attenzione alla sostenibilità ambientale e secondo le principali certificazioni di settore, sia di tipo gestionale che alimentare, etico e religioso.
Non manca anche un progetto di comunicazione e divulgazione scientifica rivolto al grande pubblico, INgredients, lanciato nel 2020 e riconoscibile come bollino applicato sul packaging dei prodotti delle aziende partner.
Di questi giorni poi è la partnership strategica con la statunitense Concerto Biosciences – leader nell’ecologia microbica - per accelerare lo sviluppo di ingredienti di nuova generazione, grazie all’integrazione tra collezioni biologiche e modelli avanzati di intelligenza artificiale. La collaborazione apre la strada a una scoperta più rapida ed efficace in ambito Food.
Un universo di competenze Made in Italy che coprono l'intera filiera agroalimentare per portare fino allo scaffale del supermercato salute, sicurezza, gusto e qualità.